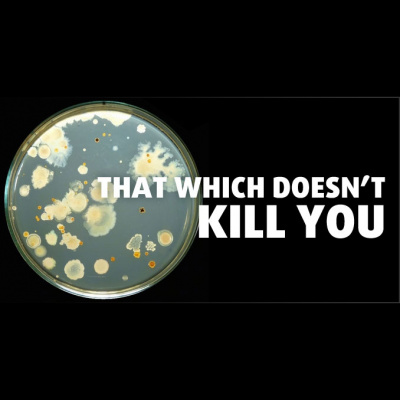
Smart Drug Smarts

Smart Drug Smarts
Hormesis
- Author: Vários
- Narrator: Vários
- Publisher: Podcast
- Duration: 0:00:00
- More information
Informações:
Synopsis
Get your smartypants ready for our year-end finale as Jesse and Dr. Edward Calabrese dive into the world of Hormesis and dose-response thresholds. The post #108: Hormesis appeared first on Smart Drug Smarts.